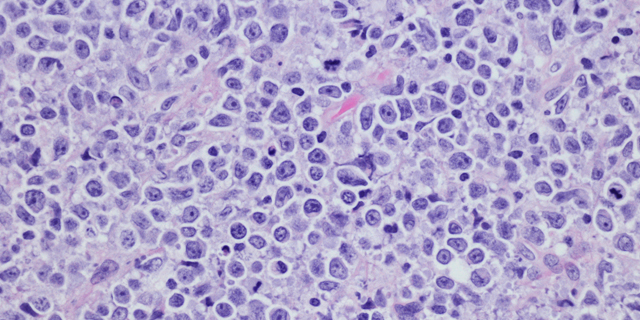

John Theurer Cancer Center Clinical Trials Pave Way for Newly Approved Lymphoma Therapies
Treatments provide new options for patients when cancer continues to grow or comes back
The U.S. Food and Drug Administration recently approved two new treatment approaches for certain types of non-Hodgkin lymphomas — umbralisib and CAR-T cell therapy — which were assessed in pioneering clinical trials at John Theurer Cancer Center at Hackensack Meridian Hackensack University Medical Center.
Lifesaving Treatment Options
Umbralisib (Ukoniq™) was approved on February 5, 2021, for patients with marginal zone lymphoma or follicular lymphoma whose cancer came back or continued to grow despite prior treatment. It works by blocking multiple enzymes involved in cancer growth. It is convenient for patients because it is a tablet that can be taken by mouth.
CAR T-cell therapy with axicabtagene ciloleucel (Yescarta®) was approved on March 5, 2021, for use in patients with follicular lymphoma that persists or recurs after two or more prior therapies.
CAR-T cell therapy involves removing immune cells called T cells from the patient. The cells are genetically modified in the laboratory to recognize certain targets and attack cancer cells. They are multiplied into the hundreds of millions and then returned to the patient’s body where they find, bind to, and kill cancer cells. The treatment is given intravenously in the hospital.
Pioneering Lymphoma Clinical Trials
Physicians in the Lymphoma Division at John Theurer Cancer Center have been at the forefront of the development of many novel therapies for lymphoma.
Lori Leslie, M.D., director of the Indolent Lymphoma and Chronic Lymphocytic Leukemia programs at John Theurer Cancer Center, is the principal investigator at Hackensack Meridian Hackensack University Medical Center for the UNITY-NHL clinical trial of umbralisib in marginal zone and follicular lymphoma, as well as the ZUMA-5 clinical trial of axicabtagene ciloleucel in patients with follicular lymphoma. The findings of these two studies led to the recent FDA approvals.
“The treatment of non-Hodgkin lymphomas is a rapidly transforming field, offering new and needed options in patients who failed standard therapies,” said Andre Goy, M.D., M.S., Chairman & Executive Director, Lymphoma Division Chief – John Theurer Cancer Center; Chief Science Officer – Regional Cancer Care Associates, Lydia Pfund Chair for Lymphoma, Professor of Medicine – Georgetown University, Professor and Chair, Dept. of Oncology, Hackensack Meridian School of Medicine. “JTCC’s broad clinical research program has allowed us to be at the forefront of these new developments and our CAR-T cell program was the first to be implemented in New Jersey and remains the lead CAR-T program in the state with trials in lymphoma, myeloma, leukemia, and now even solid tumors.”
